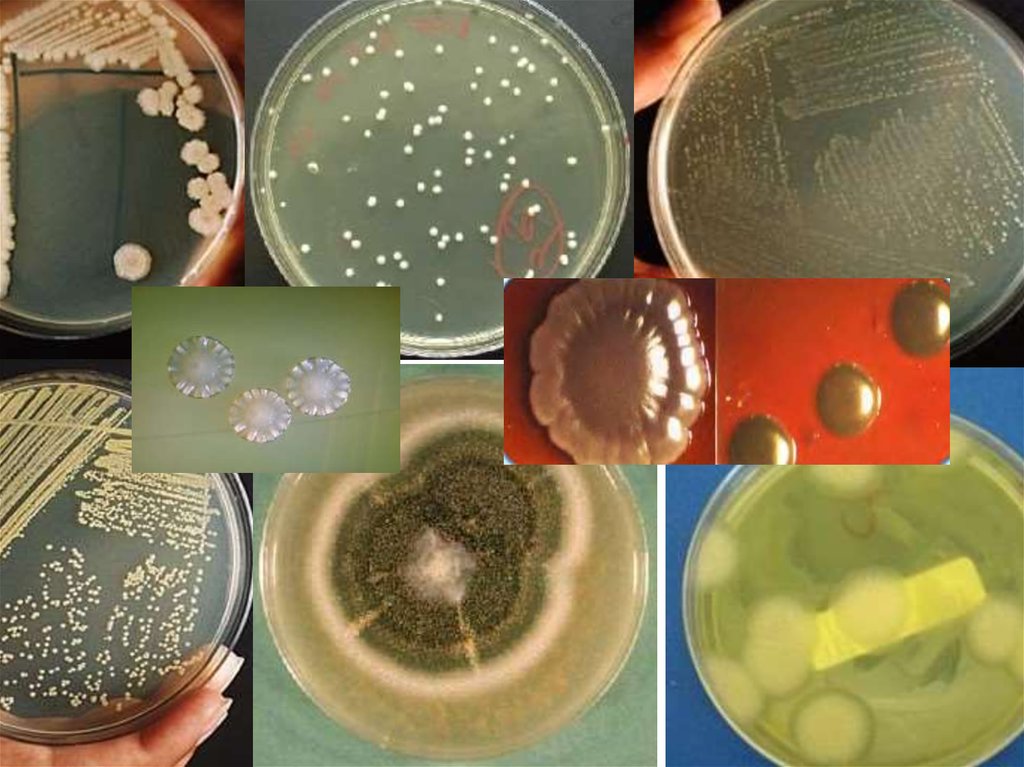
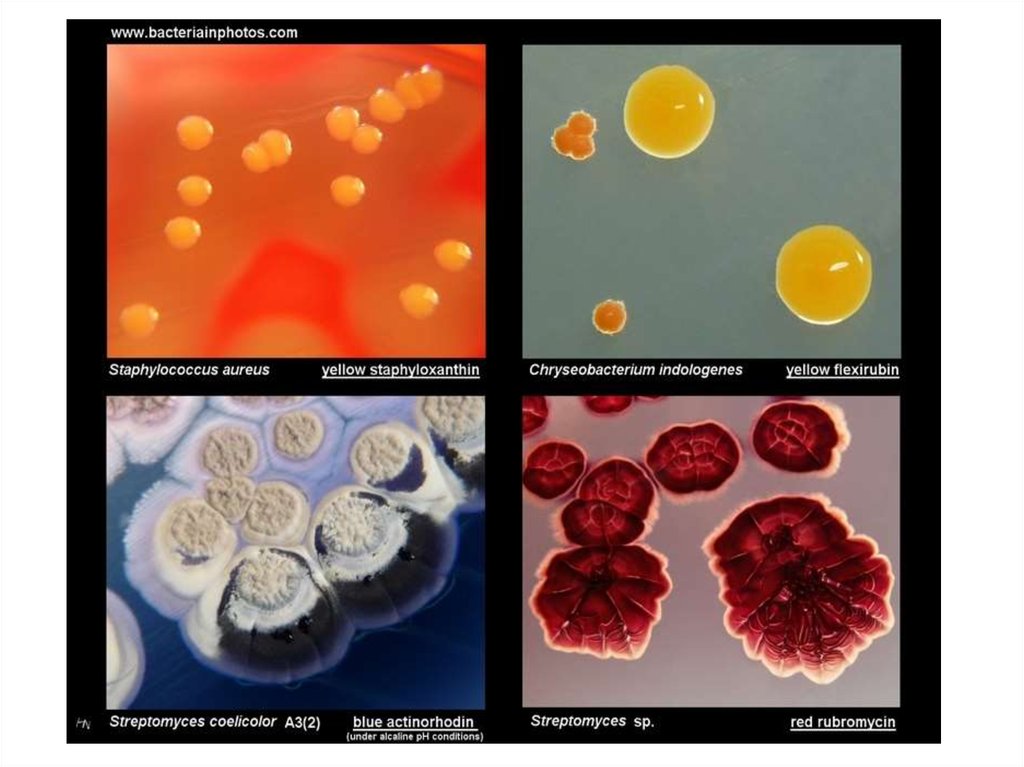
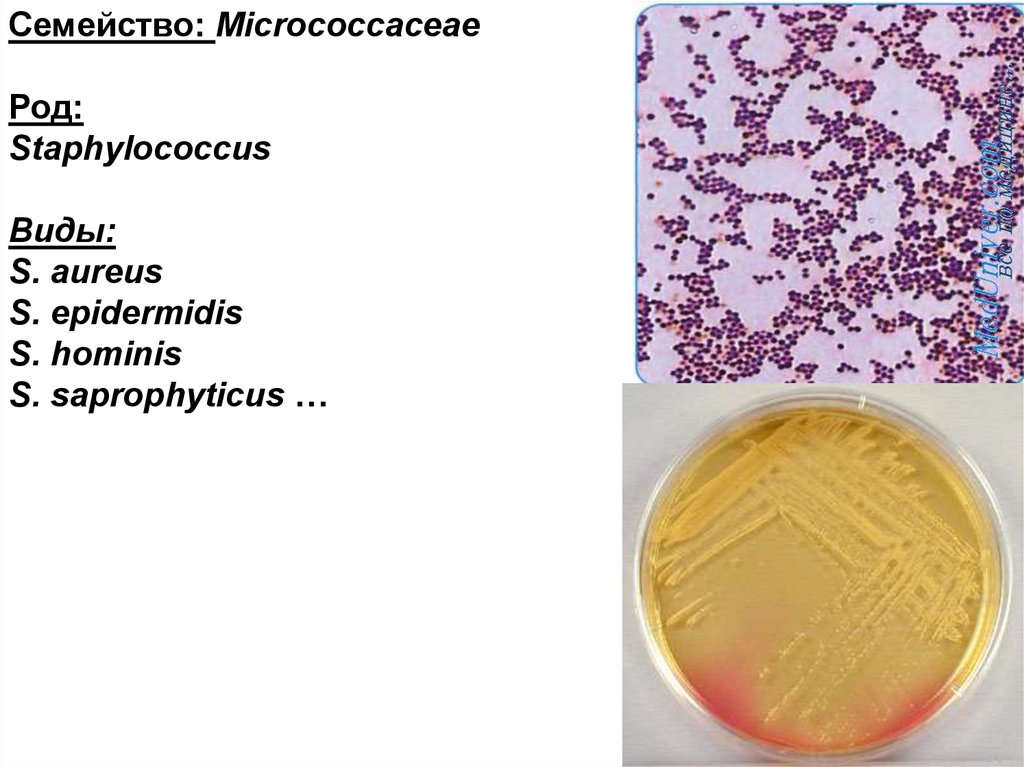
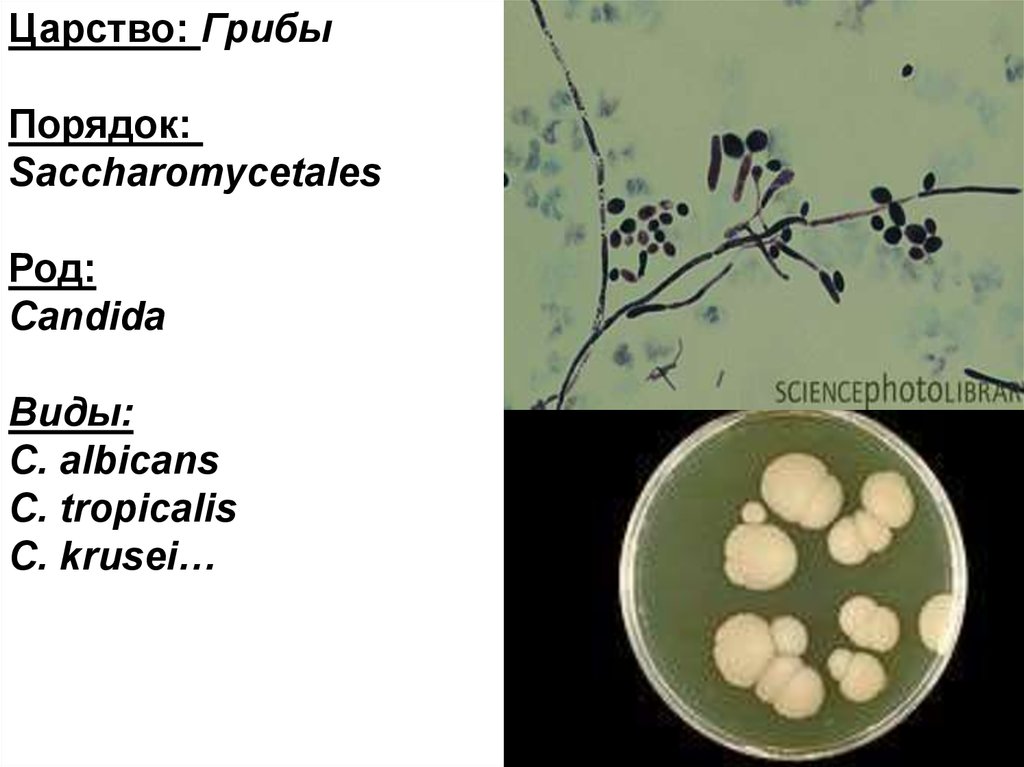
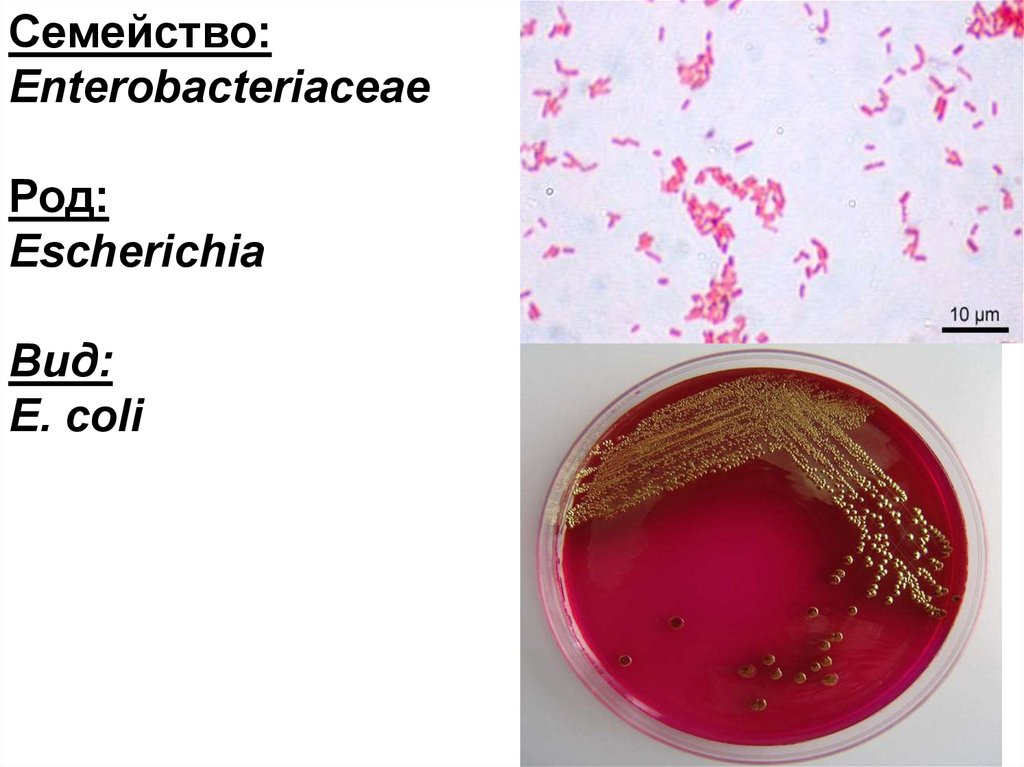

Similar presentations:
Методика выделения чистых культур. Микрофлора организма человека (2 день исследования)
1.
МЕТОДИКА ВЫДЕЛЕНИЯЧИСТЫХ КУЛЬТУР
(2 ДЕНЬ
ИССЛЕДОВАНИЯ)
МИКРОФЛОРА
ОРГАНИЗМА ЧЕЛОВЕКА
2.
3.
4.
5.
ПЛАН ОПИСАНИЯ КОЛОНИЙ1) Форма - округлая, амебовидная, ризоидная, неправильная;
2) Размер (диаметр) - очень мелкие (точечные) (0,1-0,5 мм), мелкие (0,5-3 мм), средние (3-5 мм), крупные (более 5 мм);
3) Поверхность – гладкая (smooth) – S–форма; шероховатая, складчатая,
морщинистая (rough) – R–форма, с концентрическими кругами или
радиально исчерченная;
4) Профиль - плоский, выпуклый, конусовидный, кратерообразный и
т.д.;
5) Прозрачность - непрозрачная, прозрачная, полупрозрачная;
6) Цвет (пигмент) - бесцветная или пигментированная (белая,
желтая, золотистая, красная), выделение пигмента в среду;
7) Край - ровный, волнистый, зубчатый, бахромчатый и т.д.;
8) Структура - однородная, мелко или крупнозернистая, волокнистая,
струйчатая;
9) Консистенция - плотная, мягкая, слизистая, тягучая, крошащаяся.
6.
Протокол (продолжение).Методика выделения чистых культур (2 день исследования).
Дата,
день
исследования
Исследуе
мый
материал
2 день
Рост
колоний
на чашке
с МПА
Что сделать
1) Изучить характер
роста макро- и
микроскопически
Результат
1)
2) Приготовить мазкипрепараты, окрасить по
методу Грама,
изучить морфологию,
зарисовать
3) Произвести пересев
материала из колонии
№ 1 и №2 в пробирки со
скошенным
питательным агаром
для накопления чистой
культуры
2)
Колония № 1
Колония № 2
7.
ЭКОЛОГИЯМИКРОРГАНИЗМОВ
8.
9.
ЭКОЛОГИЯ МИКРООРГАНИЗМОВ – наука,изучающая взаимосвязи между микроорганизмами в
условиях среды их обитания.
ЭКОСИСТЕМА - биологическая система, состоящая из
сообщества живых организмов (биоценоз), среды их
обитания (биотоп), системы связей, осуществляющей
обмен веществом и энергией между ними.
НОРМАЛЬНАЯ МИКРОФЛОРА – естественная
совокупность микробных популяций, наиболее часто
выделяемых из организма здорового человека,
колонизирующих различные биотопы и не
причиняющих ему видимого вреда
10.
МИКРОБИОЦЕНОЗ- совокупностьмикроорганизмов, населяющих
территорию с одинаковыми условиями
существования.
БИОТОП — относительно однородный по
абиотическим факторам среды участок,
заселённый живыми организмам
CИМБИОЗ –взаимодействие и
сосуществование представителей разных
биологических видов
11.
Типы симбиоза междумикро- и макроорганизмом:
КОММЕНСАЛИЗМ
МУТУАЛИЗМ
ПАРАЗИТИЗМ
12.
Типы симбиозамежду микроорганизмами
САТЕЛЛИЗМ
СИНЕРГИЗМ
НЕЙТРАЛИЗМ
МЕТАБИОЗ
АНТАГОНИЗМ
13.
Семейство: MicrococcaceaeРод:
Staphylococcus
Виды:
S. aureus
S. epidermidis
S. hominis
S. saprophyticus …
14.
Семейство:Streptococcaceae
Род:
Streptococcus
Виды:
S. mitis
S. mutans…
15.
Семейство:Lactobacillaceae
Род:
Lactobacillus
Виды:
L. acidophilus
L. сasei
L. salivarius
16.
Семейство:Corynebacteriaceae
Род:
Corynebacterium
Виды:
С.
рseudodiphtheriae
С. ulcerans
17.
Семейство:Neisseriaceae
Род:
Neisseria
Виды:
N. sicca
N. flava,
N. perflava
18.
Царство: ГрибыПорядок:
Saccharomycetales
Род:
Candida
Виды:
C. albicans
C. tropicalis
C. krusei…
19.
Семейство:Bifidobacteriaceae
Род:
Bifidobacterium
Виды:
B. animalis
B. bifidum
B. longum…
20.
Семейство:Enterobacteriaceae
Род:
Escherichia
Вид:
E. coli
21.
Протокол. Микрофлора организма человекаИсследуемый материал
1) Мазок-препарат из культуры
Streptococcus sрр.,
окраска по Граму
Что сделать
1) Изучить
морфологию
(демонстрация),
зарисовать.
Результат
1)
2)
2) Мазок –препарат из культуры
Lactobacillus sрр,
окраска по Граму
2) Изучить
морфологию
(демонстрация),
зарисовать.
3)
3) Мазок- препарат из культуры
Candida spp., окраска
метиленовым синим
3) Приготовить мазокпрепарат,
окрасить по методу
Грама,
изучить морфологию,
зарисовать

biology
biology








